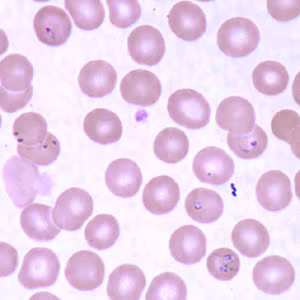

Case #160 – July, 2005
A 61-year-old New England resident was visiting his relatives in Georgia for the summer. He had recurring fevers and general weakness and at night he often experienced gastrointestinal discomfort. His relatives took him to a local hospital where he was examined and both blood and stool were collected for testing. An ova and parasite (O & P) examination was ordered for the stool specimen, and blood smears were made from the blood specimen and stained with Wrights-Giemsa. The O & P was negative for parasites. Figure A is taken from an area of the stained thick blood smear, and Figures B-D were from the thin smear. What is your diagnosis? Based on what criteria?

Figure A

Figure B
Figure C

Figure D
Images presented in the DPDx case studies are from specimens submitted for diagnosis or archiving. On rare occasions, clinical histories given may be partly fictitious.
DPDx is an educational resource designed for health professionals and laboratory scientists. For an overview including prevention, control, and treatment visit www.cdc.gov/parasites/.
